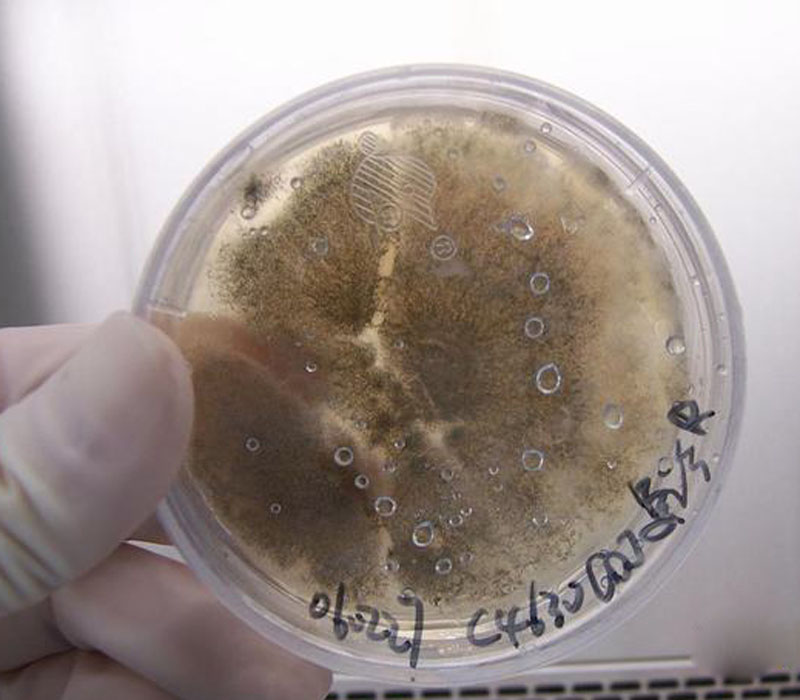
构巢曲霉

构巢曲霉
![[分享]新拍的构巢曲霉各类形态](https://imgs.wantubizhi.com/img/A1A61BAA66193547F3A6DD7D8EE527E97302CE2DDD5C557726E177F54762BA094E98DE67F3F73D650A55F09CD004D0E833BC56814F31DD76FB3CAE5002A2281093B2CCF9AB0F3FE555CFA82A9AA5354C35BE63E2300D1A49CA1BCA4D126172A7)
[分享]新拍的构巢曲霉各类形态
图片尺寸1024x736
构巢曲霉 白雅红
图片尺寸1202x902
构巢曲霉.#显微镜下的世界 #微观世界 - 抖音
图片尺寸1280x1706
构巢曲霉
图片尺寸700x1245
其次为黑曲霉,黄曲霉,构巢曲霉,青霉菌和毛霉菌等也能感染致病.
图片尺寸640x480
构巢曲霉
图片尺寸220x193
构巢曲霉
图片尺寸357x232构巢曲霉
图片尺寸800x700![[分享]新拍的构巢曲霉各类形态](https://imgs.wantubizhi.com/img/ADDA3C5D760C6828B77B505A29D43E836DB1C43E77F2727BA04F3E831611BFC90284CD55BFD3C2C039E7A1CA4AF81454201B190AFC59E8426AC5BA01519E468712B4A0E3425BE3C8ABE259EF9956AE641C54E5B8F3FA54F00404ACBED4B23087)
[分享]新拍的构巢曲霉各类形态
图片尺寸914x729构巢曲霉
图片尺寸800x700构巢曲霉
图片尺寸800x700![[分享]新拍的构巢曲霉各类形态](https://imgs.wantubizhi.com/img/ADDA3C5D760C6828B77B505A29D43E83579AD02EFEA748F0EA52C8EBFF7FB86E223B1A2A68D5ED4E8EACFA7011B8A367594F747BD0C59227329480CD4442C7DBCEBDEF885C3D3F1B993112E2B0F709867AF2E2C56B002C9E330329585FC97D78)
[分享]新拍的构巢曲霉各类形态
图片尺寸1052x724
构巢曲霉菌落培养45天 徐和平
图片尺寸1200x1200
五,构巢曲霉中等速度生长,质地绒毛状到粉状,表面绿色或黄褐色,背面
图片尺寸613x1280
构巢曲霉菌核45天 徐和平
图片尺寸1280x960
构巢曲霉的钱袋袋 白雅红
图片尺寸1280x960
构巢曲霉
图片尺寸220x193
构巢曲霉的钱袋袋 白雅红
图片尺寸1280x960
构巢曲霉菌培养物镜下可见菌丝体,分生孢子头,分生孢子.
图片尺寸660x614
自己拍的曲霉图片,请欣赏
图片尺寸912x867
![[分享]新拍的构巢曲霉各类形态](https://bbs.sific.com.cn/data/attachment/forum/month_0806/20080604_09c3dadd472699ff06009vLE35S2uAuQ.jpg)







![[分享]新拍的构巢曲霉各类形态](https://bbs.sific.com.cn/data/attachment/forum/month_0806/20080604_2d411089d5e48a971856GFG2xvBnJv3a.jpg)

![[分享]新拍的构巢曲霉各类形态](https://bbs.sific.com.cn/data/attachment/forum/month_0806/20080604_d6c859f44896f88521fdrMNax5LdaY3m.jpg)







